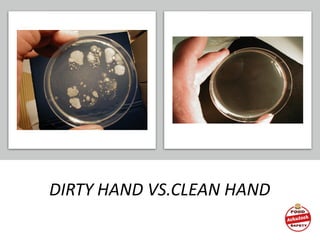
DIRTY HAND VS.CLEAN HAND
78

Ashutosh Jaiswal is a quality and food safety manager with 9 years of experience in food manufacturing, catering, and hospitality industries across India, GCC and Africa regions. He has conducted over 800 training batches training over 15,000 candidates in food safety. He has also conducted over 300 food safety audits and implemented several food safety standards in over 50 food manufacturing organizations. The document discusses food safety management systems and various prerequisite programs including premises, transportation and storage, equipment, traceability and recall, and supplier quality assurance. It covers topics such as site selection, design of food premises, cleaning and sanitation, personal hygiene, pest control, temperature control, and supplier approval.